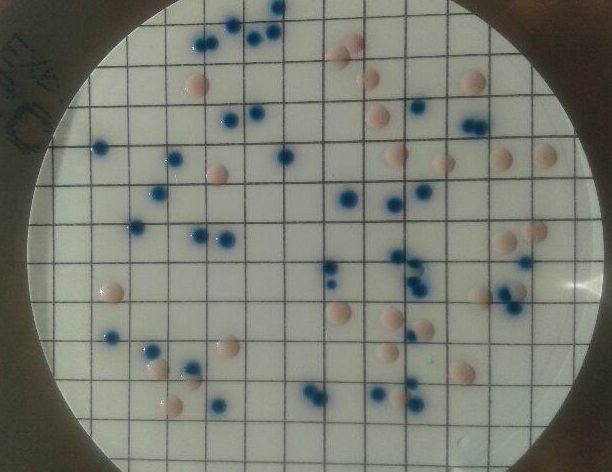

ROZSZERZENIE ZAKRESU BADAŃ WODY
Dnia 19.04.2018 roku Państwowy Powiatowy Inspektor Sanitarny w Braniewie zatwierdził system jakości badań wody do spożycia w zakresie „Ogólnej liczby mikroorganizmów w temperaturze 22 ° C” oraz „Wykrywanie i oznaczanie enterokoków kałowych” – prowadzony w Laboratorium Wodociągów Miejskich.
Tym samym Laboratorium wykonuje badania jakości wody pod względem mikrobiologicznym w pełnym zakresie określonym w Rozporządzeniu Ministra Zdrowia z dnia 7 grudnia 2017 roku w sprawie jakości wody przeznaczonej do spożycia przez ludzi (Dz.U. 2017 poz. 2294) dla parametrów grupy A.
1. Liczba bakterii z grupy coli – PN-EN ISO 9308-1:2014
2. Liczba Escherichia coli – PN-EN ISO 9308-1:2014
3. Liczba Enterokoków kałowych – PN-EN ISO 7899-2:2004
4. Ogólna liczba mikroorganizmów w temperaturze 22 ° C – PN-EN ISO 6222:2004
Zdjęcie: G. Binięda Bakterie Grupy Coli i Escherichia Coli.

Zdjęcie: G. Binięda Enterokoki kałowe.
